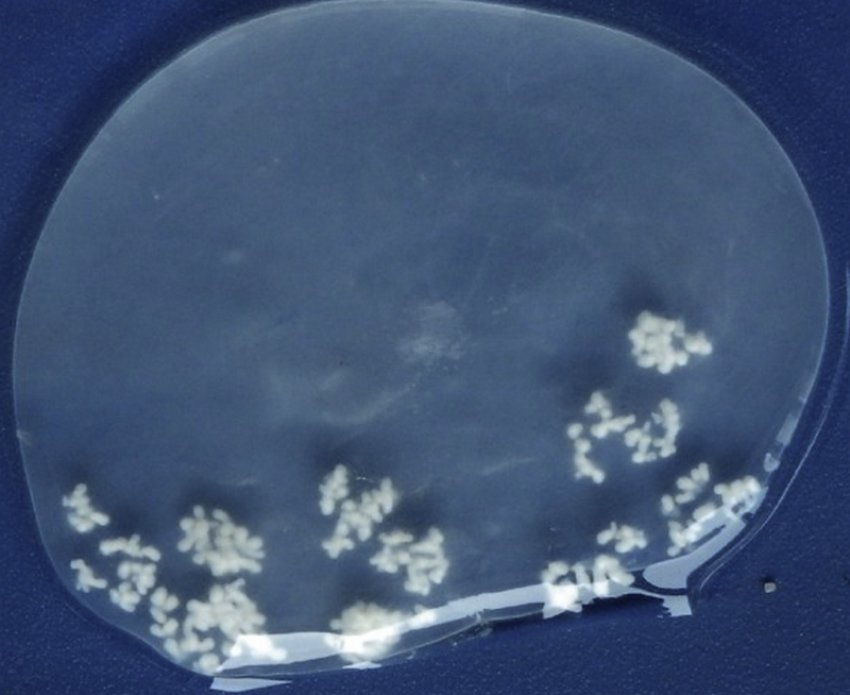
Міхур (кіста) зі сколексами

Овечий мозговик - один із поширених гельмінтів, що призводить до тяжких наслідків для здоров'я овець. У рідкісних випадках заразитися ним можуть і люди. Нижче описано особливості цього паразита, симптоми спричиненої ним хвороби та її лікування, а також методи профілактики зараження.
Характеристика збудника
Мозговик овечий (або мультицепс) є стрічковим черв'яком, який належить до загону циклофілід. Його личинки найчастіше паразитують у головному мозку овець, що пояснює назву гельмінта. Також гельмінт іноді вражає кіз і велику рогату худобу.
Біологічний опис
Характерними біологічними ознаками дорослої особини цього виду хробака вважаються:
- загальна довжина до 10 см, але багато джерел наводять цифру 50-100 см;
- головка з 4-ма присосками;
- хоботок озброєний 22-32 гаками;
- тіло складається з 200-250 члеників.

Особливості життєвого циклу
Особливістю паразитів цього типу є різне середовище проживання у дорослих особин і личинок. Статевозрілі черв'яки мешкають у сімействі псових, у кишківниках собак, вовків, шакалів і лисиць, а цінури розкриваються у проміжних господарів - овець або людей.

Життєвий цикл мультицепса має таку послідовність:
- Яйця гельмінта, що потрапили в організм тварини з водою або травою, розкриваються і онкосфера (початкова стадія личинки), потрапивши в кров, добирається до головного мозку.
- Ценура (наступна стадія личинки) викликає смертельне захворювання проміжного господаря.
- Заражені частини полеглої тварини з'їдає собака або лисиця. У їхньому кишечнику після статевого розмноження дорослих черв'яків утворюються нові яйця, які з калом виводяться назовні і потрапляють на траву або у воду.
Причини та ознаки зараження
Овечий мозочник викликає у проміжних господарів цінуроз. Захворювання є, найчастіше, хронічним і супроводжується ураженням головного (рідко спинного) мозку. Народна назва хвороби - вертячка, вертеж або мозольник, що описує одну з характерних особливостей поведінки тварин.
Патогенез і симптоматика
Потрапивши в головний мозок, через 3-6 місяців, з онкосфер формуються центури, які потім призводять до вогнищевих уражень і руйнують тканини. У середньому, в однієї вівці знаходять 1-3 центури, але бувають випадки виявлення і 20-30 штук.
Міхур личинки (кіста) тисне на мозкову тканину, а в деяких випадках може тиснути й на кістки черепа, стоншуючи та навіть продірявлюючи їх. Прояв зовнішніх симптомів залежить від місця розташування личинок у мозку, їхньої кількості та загального стану тварини.
Найхарактернішими симптомами у овець є:
- кругові мимовільні рухи;
- стрімкий біг або довге стояння, з упором головою в предмет;
- порушення рівноваги, частковий параліч;
- звішування голови набік, опускання вух;
- втрата апетиту і порушення зору;
- почервоніння сполучної оболонки очей.

Шкода для тварин і людей
Без своєчасної діагностики та лікування, цінуроз призводить до летального результату для людей і тварин. У неблагополучних господарствах фіксують до 20% ураження молодняка. Хвороба призводить до падежу худоби, втрат вовни та м'ясопродуктів, додаткових витрат на догляд і лікування.
Стадії перебігу
Перші прояви зараження можуть бути помічені через 2-3 тижні після потрапляння збудників в організм. Тварина стає полохливою, проявляє періодичне збудження, можливі судоми.
Слабкі ягнята іноді гинуть уже в цей період, але у більшої частини ознаки пропадають на 2-6 місяців. Друга стадія проявляється переліченими вище типовими симптомами, після чого цінуроз переходить у заключну стадію.

Як визначити захворювання та вилікувати худобу
Ветеринар ставить діагноз, об'єднуючи клінічну картину хвороби та відомості про епідеміологічну історію тварини, а також використовує дослідження черепа та огляд очного дна. Для лікування на ранніх стадіях використовують ін'єкції 5% настоянки йоду і препарат панакур (антигельмінт), а на пізніх стадіях може застосовуватися хірургічне видалення ценур.
Випадки та симптоми зараження людини
Людина рідко хворіє на ценуроз, але небезпека хвороби для неї так само велика, як і для овець. Заразитися можна під час контакту з шерстю або язиком собаки, що є господарем гельмінта. Також шляхами передачі яєць паразитів можуть бути вода, трава або ґрунт, на які потрапили заражені фекалії собак.

До основних ознак відносять:
- постійний головний біль;
- запаморочення, нудоту і блювоту;
- втрати свідомості та дезорієнтацію;
- ригідність м'язів на потилиці;
- судоми.
Для діагностики використовують дослідження мозку (УЗД, МРТ і КТ) та неврологічний огляд. Лікування найчастіше проводять хірургічним методом, іноді використовують хіміотерапію.
Поширення
До зараження схильні регіони з розвиненим вівчарством, де не приділяється достатньої уваги контролю над бродячими тваринами. На небезпеку наражаються працівники ферм, які мають часті близькі контакти з собаками. Досвідчені вівчарі зазначають, що найбільш схильні до гельмінту тонкорунні породи в перший рік життя ягнят.

Профілактика
Для профілактики зараження проводять поголовну вакцинацію ягнят, яка дає змогу за 3-4 роки застосування звільнити тваринницьке господарство від ценурозу.
Додатковими заходами захисту є:
- регулярна дегельмінтизація пастуших собак;
- вилов бродячих собак, запобігання їхньому контакту з отарою;
- дезінфекція кошарок і сараїв.








